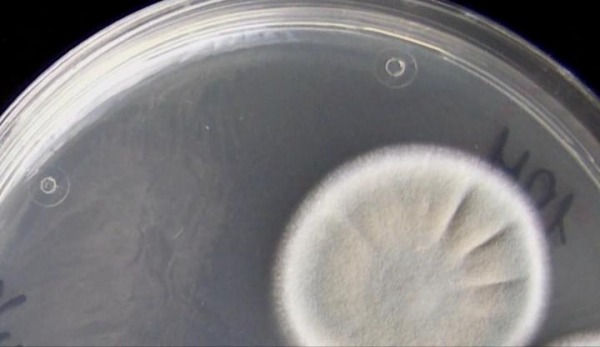
5

Этот ресурс создан для настоящих падонков. Те, кому не нравятся слова ХУЙ и ПИЗДА, могут идти нахуй. Остальные пруцца!
Кто боится Ктулху? Плесень зохавает ваш Моск!
Страна: Россия
Год: 2009
Продолжительность: 97 мин
В детстве у меня был товарищ, которого иногда посещали очень ебанутые мысли и его креативность не раз вводила меня ступор. Так однажды он поспорил с другим моим товарищем, по теме слабо – не слабо, залез на стрелу крана и с высоты воробьиного полета посрал на новостройку. Прошло много лет и теперь я займусь примерно тем же, залезу в Ворд и посру на новый научно-ф-популярный фильм «Плесень».


В школе я не был лучшим учеником, и биологией увлекался больше по книгам Гарри Гаррисона «Неукротимая планета», там были всякие ацкие животные с кислотой вместо крови и скверным нравом. Тем не менее, даже такому дилетанту как я, показалось несколько натянутой связь плесени с чумой и проказой. Недолго думая, нырнул в просторы порноокеана и меж статей про хуй-пезду нашел несколько линков о грибочках и бактериях. Почитал, интересно. Пришел к однозначному выводу, что фильм «Плесень» лишь подтверждает мое мнение о профессионализме российского кинематографа, теперь уже и научного, открывая новый неизученый жанр научно-ф-популярного кино.


Весь фильм нам усердно предлагают поверить в то что наш моск давно зохавала плесень и она же управляет нашим сознанием, это все плесень организовала крестовые походы, первую и вторую мировые, эпидемии чумы, чумку и волчанку у создателей фильма и проказу. Плесень живет в космосе, плесень хуй убъешь, плесень благо, плесень проклятие, плесень то, плесень это.. плесень, плесень, плесень. Через каждые два слова «плесень» и «именно она», причем о самой плесени есть лишь общеизвестные факты и какие то мистические пляски в стиле «миня спиздили инопланетяне, но я все равно богоизбран» добрую половину фильма снабдили историческими вкладками. Среди них героическое противустояние графа Орлова мору в Москве и чудодейственность колокольного звона (тут подпрыгиваем в танце), станцию Мир съела плесень надо затопить (бьем в бубен), чума это тоже плесень(начинаем шептать слова заклинания) и человек тоже Гриб (падаем в экстазе, и неистово дрочим на сенсацию).


Безусловно есть интересные моменты, но так как цель кретива кАкнуть со стрелы крана в душу создателям фильма, то мы их опустим. Тут приготовьте гигиенические пакеты, повествование ведет проникновенным голосом берёзок, заслуженный гриб, бригадир всея Руси, Саша Белый Каппель Безруков. Он поведал нам, что оказывается за звание венец природы в тяжёлом весе ведут бой уже не одно тысячелетие, Человек и Плесень, причем у человека шансов нет никаких, лишь сторонники в лице пенициллина и сыра Рокфор. После таких откровений я решил, что фильм по своей фантастичности ничуть не уступает «Неукротимой планете» и с радостью захотел представить его Вам.


Похвально, что в России пытаются возродить жанр, до бибиси и нэшнл джиографик конечно как Козачку до Китая, да и не надо на них равнятся, снимали же в СССР хорошие научные фильмы. Да, иногда скучно, заумно, но не откровенный же пиздеж теперь показывать. Разбавить художественными сюжетами можно, но нельзя акцентировать внимание на околонаучных недоказанных гипотезах в поиске сенсаций и ради сочности повествования, говорить что хорошее настроение и дисциплина победило чуму. Смешав божий дар с мухами и перепутав котлеты с яйцами, щедро посыпав сверху Безруковым нам предлагают скушать несвежий заплесневевший продукт.



Поэтому ниибите моск и если хотите приобщица к науке с пользой и позитивом, смотрите фильм про смешных жывотных Сурикатов/ Meerkats, тут и драма, и комедия, и непредсказуемые сюжетные ходы и актеры смешнее Джима Керри и Безрукова нет, а есть Пол Ньюман закадром и пустыня Калахари с такими человечными обитателями, что действительно переживаешь за этих маленьких говнюков.



Год: 2009
Продолжительность: 97 мин
В детстве у меня был товарищ, которого иногда посещали очень ебанутые мысли и его креативность не раз вводила меня ступор. Так однажды он поспорил с другим моим товарищем, по теме слабо – не слабо, залез на стрелу крана и с высоты воробьиного полета посрал на новостройку. Прошло много лет и теперь я займусь примерно тем же, залезу в Ворд и посру на новый научно-ф-популярный фильм «Плесень».


В школе я не был лучшим учеником, и биологией увлекался больше по книгам Гарри Гаррисона «Неукротимая планета», там были всякие ацкие животные с кислотой вместо крови и скверным нравом. Тем не менее, даже такому дилетанту как я, показалось несколько натянутой связь плесени с чумой и проказой. Недолго думая, нырнул в просторы порноокеана и меж статей про хуй-пезду нашел несколько линков о грибочках и бактериях. Почитал, интересно. Пришел к однозначному выводу, что фильм «Плесень» лишь подтверждает мое мнение о профессионализме российского кинематографа, теперь уже и научного, открывая новый неизученый жанр научно-ф-популярного кино.


Весь фильм нам усердно предлагают поверить в то что наш моск давно зохавала плесень и она же управляет нашим сознанием, это все плесень организовала крестовые походы, первую и вторую мировые, эпидемии чумы, чумку и волчанку у создателей фильма и проказу. Плесень живет в космосе, плесень хуй убъешь, плесень благо, плесень проклятие, плесень то, плесень это.. плесень, плесень, плесень. Через каждые два слова «плесень» и «именно она», причем о самой плесени есть лишь общеизвестные факты и какие то мистические пляски в стиле «миня спиздили инопланетяне, но я все равно богоизбран» добрую половину фильма снабдили историческими вкладками. Среди них героическое противустояние графа Орлова мору в Москве и чудодейственность колокольного звона (тут подпрыгиваем в танце), станцию Мир съела плесень надо затопить (бьем в бубен), чума это тоже плесень(начинаем шептать слова заклинания) и человек тоже Гриб (падаем в экстазе, и неистово дрочим на сенсацию).

Безусловно есть интересные моменты, но так как цель кретива кАкнуть со стрелы крана в душу создателям фильма, то мы их опустим. Тут приготовьте гигиенические пакеты, повествование ведет проникновенным голосом берёзок, заслуженный гриб, бригадир всея Руси, Саша Белый Каппель Безруков. Он поведал нам, что оказывается за звание венец природы в тяжёлом весе ведут бой уже не одно тысячелетие, Человек и Плесень, причем у человека шансов нет никаких, лишь сторонники в лице пенициллина и сыра Рокфор. После таких откровений я решил, что фильм по своей фантастичности ничуть не уступает «Неукротимой планете» и с радостью захотел представить его Вам.


Похвально, что в России пытаются возродить жанр, до бибиси и нэшнл джиографик конечно как Козачку до Китая, да и не надо на них равнятся, снимали же в СССР хорошие научные фильмы. Да, иногда скучно, заумно, но не откровенный же пиздеж теперь показывать. Разбавить художественными сюжетами можно, но нельзя акцентировать внимание на околонаучных недоказанных гипотезах в поиске сенсаций и ради сочности повествования, говорить что хорошее настроение и дисциплина победило чуму. Смешав божий дар с мухами и перепутав котлеты с яйцами, щедро посыпав сверху Безруковым нам предлагают скушать несвежий заплесневевший продукт.



Поэтому ниибите моск и если хотите приобщица к науке с пользой и позитивом, смотрите фильм про смешных жывотных Сурикатов/ Meerkats, тут и драма, и комедия, и непредсказуемые сюжетные ходы и актеры смешнее Джима Керри и Безрукова нет, а есть Пол Ньюман закадром и пустыня Калахари с такими человечными обитателями, что действительно переживаешь за этих маленьких говнюков.



— Makumba , 29.04.2009
ВНИМАНИЕ!
наш домен плавно и не спеша переезжает на udaff.online
в связи со смертью Профорга домен udaff.com перестанет быть доступен весной.
мы установили переадресацию на udaff.online, чтобы вы привыкли.
рекомендуем в закладках изменить udaff.com на udaff.online
наш домен плавно и не спеша переезжает на udaff.online
в связи со смертью Профорга домен udaff.com перестанет быть доступен весной.
мы установили переадресацию на udaff.online, чтобы вы привыкли.
рекомендуем в закладках изменить udaff.com на udaff.online


НИИ БЁТ, 29-04-2009 10:04:50
а таг ?
13507167Гарррбатый, 29-04-2009 10:05:07
и таг!
13507170Гарррбатый, 29-04-2009 10:05:32
а есле НИИ БЁТа с Марусей стравить..кто кого заборет?
13507173Бенжамин Франклин 2 Лысый, 29-04-2009 10:11:50
большэ плесени - штоп всё заволосилось.
13507222ебатьколотить, 29-04-2009 10:13:34
всем звонить колоколами и будет счастье !!
13507227ебатьколотить, 29-04-2009 10:17:42
на 11-ой фотге раскрывается тема "Фкусно жрать"
13507266Уибантуз, 29-04-2009 10:18:09
Аффтар, пра плесень уже не актуально, давай уже хуярь пра сурикатов.
13507270старый ебучий пердун, 29-04-2009 10:25:50
Отлично сказал.
135073366*
Суровый чилябенскей Лиоха, 29-04-2009 10:32:46
в роли плесени - Сырожа Бизрукафф
13507367Суровый чилябенскей Лиоха, 29-04-2009 10:39:05
у мну на работе валялсо пакетик с сухареками, я пра нево забыл савсем, а тут абнаружил и давай их точить, фтыкая в удаф.ком, чуствую - что-та со вскусом не то, гляжу, а там ПЛЕСЕНЬ, а я ведь часть съел. Вот у меня вопрос теперь: плесень с сухарикаф сможет из жылудка пралесть в мой моск и как ана будит мной управлять? И ваабще, плесень с какова продукта предпочтительнее для контроля над человеком?
13507415Суровый чилябенскей Лиоха, 29-04-2009 10:40:22
а ваабще, цурикаты б/п симпатичнее плесени и уж тем более безрукова
13507430Фанат Кати Гамовой, 29-04-2009 10:50:02
на бибиси и нейшенл джиографик тоже дохуя говна всякого снимают. фильм - псевдонаучная хуита. аффтар исследует псевдонаучную хуиту, следовательно его моск безнадежно заплесневел (см. фото 8)
13507511ЖеЛе, 29-04-2009 11:06:12
панятно... зачол... токо не увидел абаснованной критеки - так, чисто "покакать со стрелы"...
13507580Воспитатель дебилов, 29-04-2009 11:08:39
Про сурикатов смотрел. Плесень в пизду, там ей самое место.
13507616Ахуефшый бапкин внуг, 29-04-2009 11:10:16
Аффтар- псевдонаучный мудаг. Сматри Ну пагади.
13507631Хуй с гары, 29-04-2009 11:24:26
ответ на: Суровый чилябенскей Лиоха [10]
Высрешь с паносом, да и фсё.
13507744ekzoman, 29-04-2009 11:40:20
па тиливизару паказыали хуй знаит когда, не удивил.
13507864ekzoman, 29-04-2009 11:42:18
ответ на: Суровый чилябенскей Лиоха [11]
13507884Старичюля, 29-04-2009 11:58:46
Давай сцылу на фильму про цурикатофф!
13508047Don Pablo, 29-04-2009 12:08:28
Плесень вас заебёт! Ни смотрел и не буду. Вылез из лесу в город - все вокруг пиздят о плесени. Прошло какое-то время, опять в город заглянул - все вокруг пиздят о каком-то фильме про вред олкоголизьма. Причём пиздят точно такими же словами, с такими же ахуями и т.д.
13508125Господа, на вас дятьки из зомбоящега какие-то эксперименты ставят, а эти фильмы - этапы большого пути. Пошлите их на хуй и не смотрите следующий фильм.
Лиссабонец, 29-04-2009 13:07:46
Что за педофилия на фото N13?
13508570Суровый чилябенскей Лиоха, 29-04-2009 13:16:24
нет, не вижу. а ты видишь свой мозг? ахуенный у тибя кругазор
13508623ЙЙЙ, 29-04-2009 14:05:13
Блять,аб этам фильме забыл уже ,а тут нака,сукаблятьнахуй-апзор
13509024ЙЙЙ, 29-04-2009 14:05:55
откель ты сердешный выпал?
13509031Хранительница личностных матриц, 29-04-2009 14:46:32
у меня и так плесени в жизни полно
13509378Makumba, 29-04-2009 15:02:52
ответ на: ЖеЛе [13]
обоснованная критика есть в инете, слишком много заумных слов и терминов
13509580Makumba, 29-04-2009 15:04:07
ответ на: Ахуефшый бапкин внуг [15]
спасибо посмотрю, йуморист
13509594Makumba, 29-04-2009 15:04:42
ответ на: ekzoman [17]
звиняй тилевизора дома нет
13509606Makumba, 29-04-2009 15:07:56
старичуля, есть такой поисковик гугль можешь воспользоваься им
13509629Makumba, 29-04-2009 15:09:39
ответ на: Хранительница личностных матриц [25]
ай-яй-яй, зачем же так запускать?
13509646Русскоязычная, 29-04-2009 15:15:01
плесневелые фотки понравелись
13509677telejkina, 29-04-2009 15:19:37
бля, меня давеча адин знакомый на полном серьезе уверял што если в доме хоть рас появилас плесень то дом нада сжигать
13509703я чото так ржала што даже забыла утачнить - с абетатиляме или можно бес
Makumba, 29-04-2009 15:20:52
ответ на: telejkina [32]
насмотрелся вот таких фильмов, и вот результат
13509710Берсеркер, 29-04-2009 15:24:06
ответ на: ekzoman [18]
Поставил как фон в мобиле. Теперь на меня глядит сурикат.
13509735Сварщег аццких волокон, 29-04-2009 15:56:21
Моск аффтара зохавала плесень. Ф топку.
13509977ekzoman, 29-04-2009 16:04:28
ответ на: Берсеркер [34]
гыгы, сам ищу большую картинку, на рабочий стол.
13510045Смох, 29-04-2009 17:43:36
куда катиццо кк? куда катиццо удафком? куда катиццо ваабще фсе это бляццтво?
13511112я забыл подписацца, асёл, 29-04-2009 21:03:39
а плесень мой лучшый таварищь и друк и в радости и в горе
13513044Дед Пахом, и трахтор в Ночном, 30-04-2009 07:08:05
Бля а мухаморы с плесенью жрать тоже нельзя?
13515572Фюрер, 30-04-2009 08:57:34
да, первое впечатление такое и было, всё пиздец, приехали....жыли не тужили, а тут хуйак нашествие плесени, надо срочно звонить людям в черном, агентам джейю и кейю
13515700Говножопый хуепиздрик, 30-04-2009 09:20:21
На пятой картинге гондон чтоль дном банке раздавилле?
13515735Мишка с прайебаной улыппкой, 30-04-2009 11:00:49
Плесень - наше всио!
13516479Дорогая плесень убей пжалуста Михоила Маковеццкого и всех мущщин АнныОркан.
Грибник, 02-05-2009 14:54:55
про Красную Плесень
13535695Грибник, 02-05-2009 14:55:57
Вампир Кашолкин, это был он
13535706Вампир Кашолкин, это был он